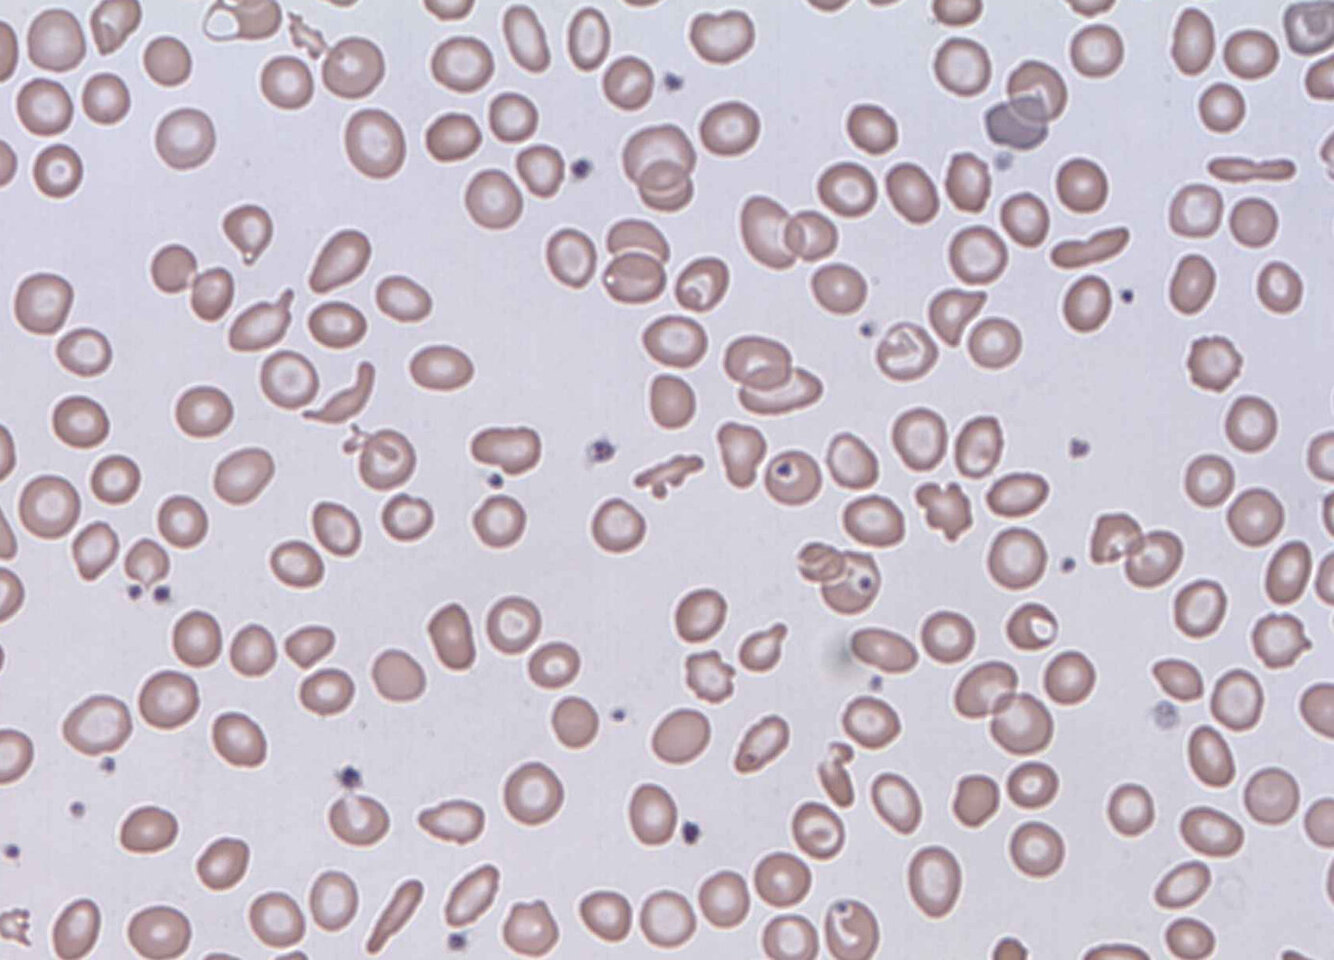

Macroangiopathic hemolytic anemia
caused by mechanical destruction of erythrocytes in the systemic circulation. Prosthetic heart valves are a known cause of macroangiopathic hemolysis
What does the smear show?
Fragmented erythrocytes, which are convex on one side (examples indicated by blue lines) and concave on the other (examples indicated by yellow lines), are visible among the normal erythrocytes. These fragmented erythrocytes are referred to as schistocytes.
Haptoglobin interpretation
- Decreased: Intravascular hemolysis
- Normal: Extravascular hemolysis
XXXXXX is the most common cause of community-acquired pneumonia and sepsis in patients with SCD.
Streptococcus pneumoniae is the most common cause of community-acquired pneumonia and sepsis in patients with SCD.
Reciprocal translocation 15, 17
Acute promyelocytic leukemia
M3 variant
Tx: Vit A (All-trans retinoic acid, ATRA)

Smudge cells
remnants of abnormally fragile lymphocytes that have ruptured. This finding is not exclusive to chronic lymphocytic leukemia but is often present and considered pathognomonic for this condition
The most common cause of generalized lymphadenopathy in > 65 year olds
Chronic lymphocytic leukemia
Low leukocyte alkaline phosphatase (LAP) is a distinct feature of
Chronic myelocytic leukemia
Also t(9;22) translocation (Philadelphia chromosome)
Tx: imatinib
Dx?
Myeloperoxidase-positive granules
Myeloperoxidase-positive granules are a typical finding in the blast cells of AML and differentiate AML from acute lymphoblastic leukemia, which is characterized by blast cells that are myeloperoxidase negative
CD15/30 positive cells
Hodgkin lymphoma
Finding associated with poor prognosis in Hodgkin lymphoma, non-Hodgkin lymphoma, testicular cancer, Acute myelogenous leukemia
High LDH
B symptoms, painless lymphadenopathy, anemia, and an increased serum lactate dehydrogenase (LDH). In conjunction with CD20 on malignant lymphocytes
Diffuse large B-cell lymphoma
most common non-Hodgkin lymphoma in adults
Diffuse large B-cell lymphoma
Most common cause of hyperCa++ in Hodgkin Lymphoma
Ectopic vitamin D production as a result of increased 1α-hydroxylase activity in proliferating lymphoid tissue is the most common cause of hypercalcemia in patients with Hodgkin lymphoma


